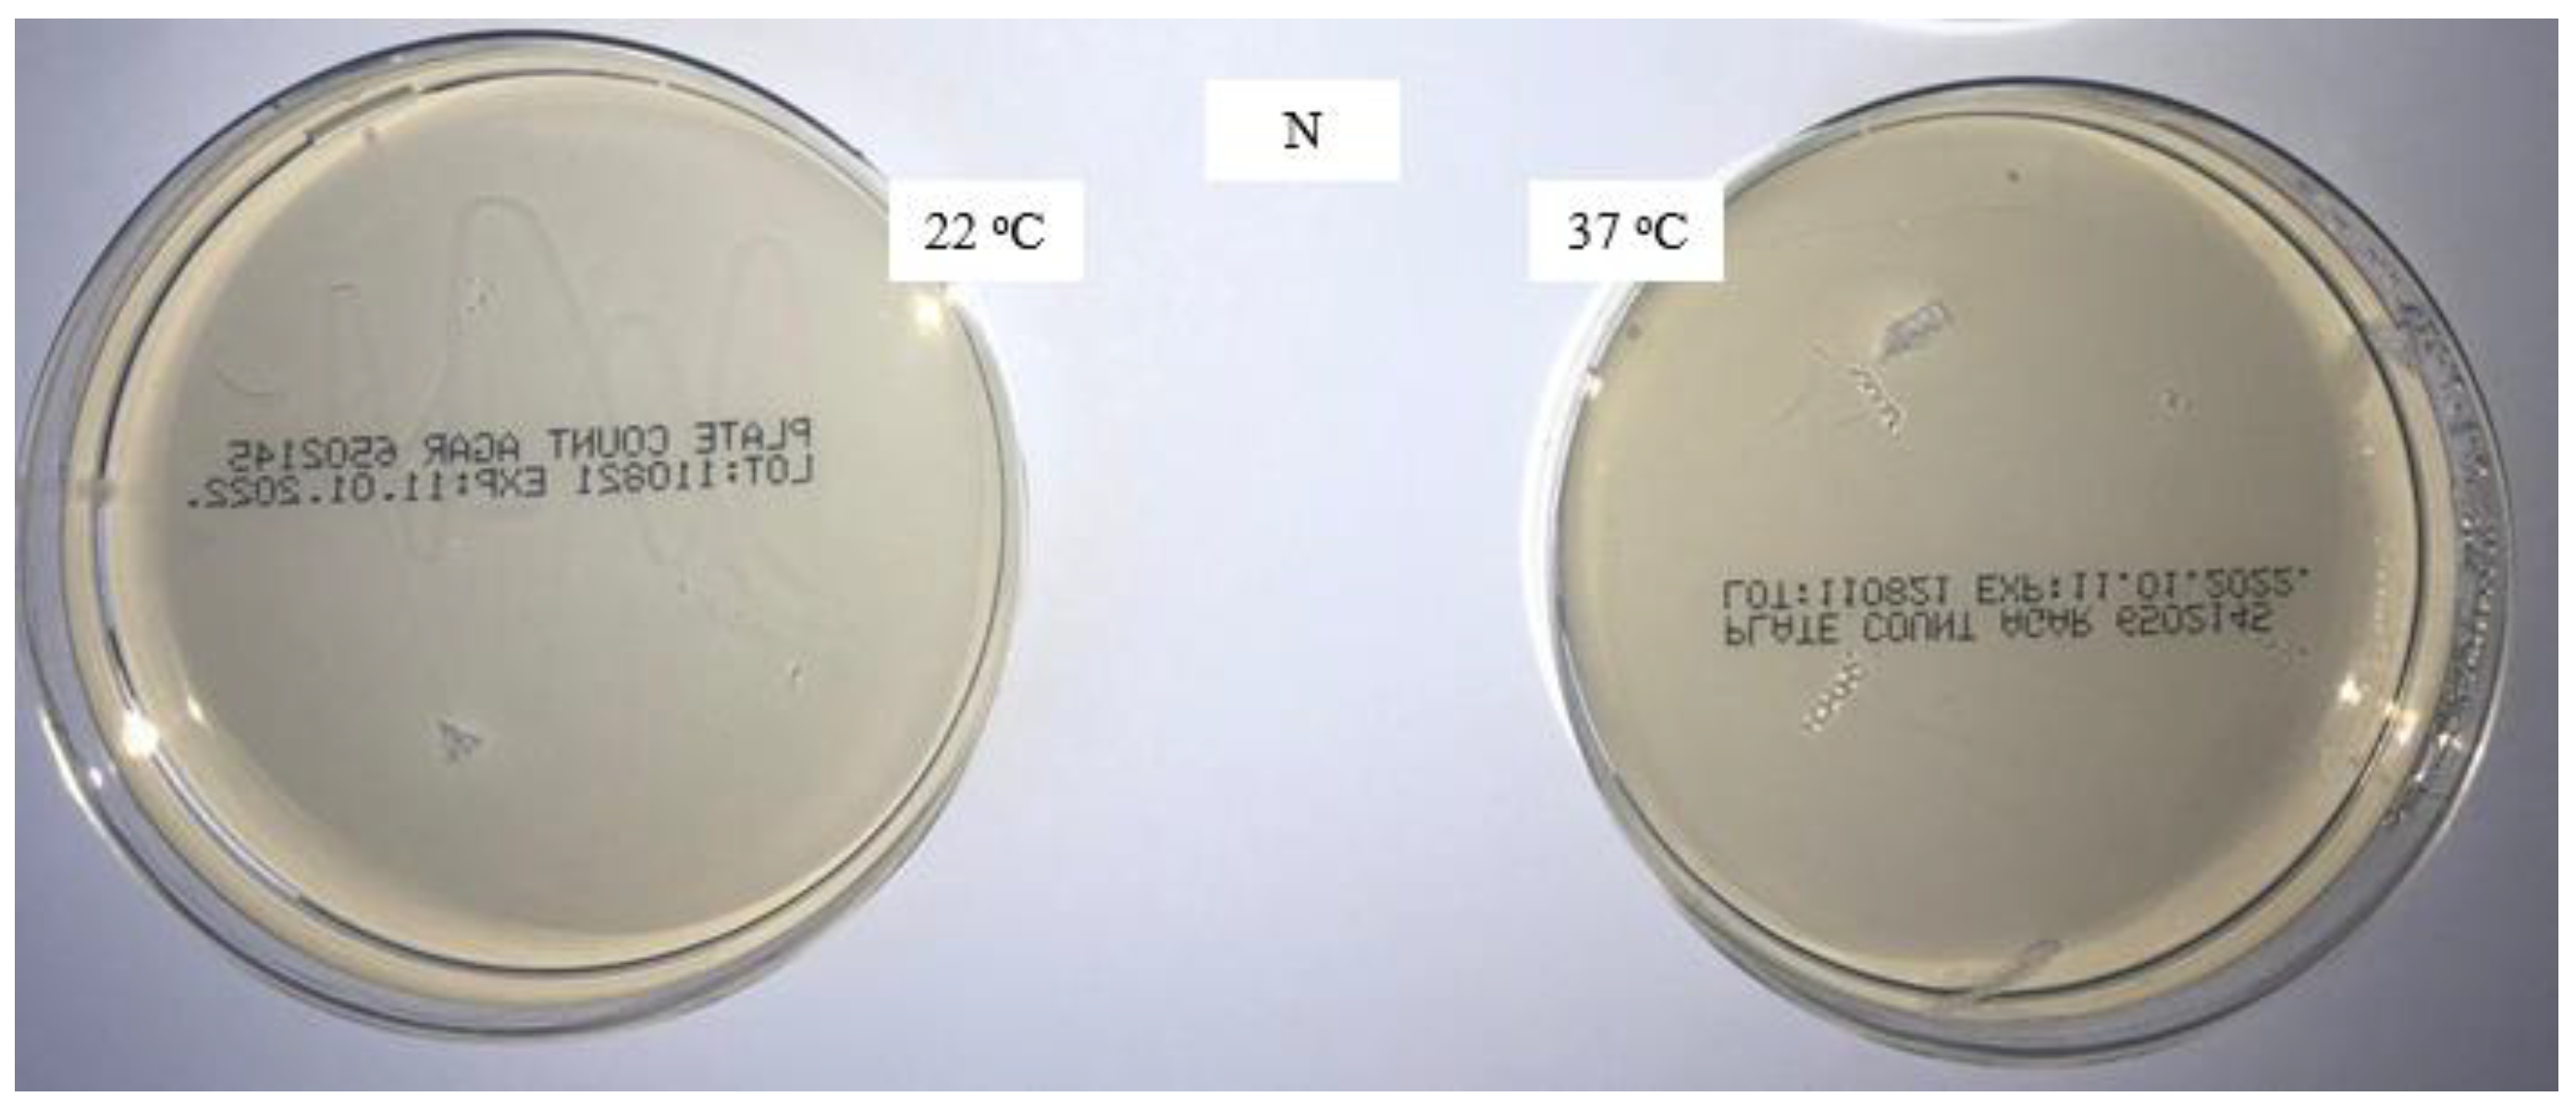
Materials 16 01247 g001

The aqueous extract of the whole mask samples before and after washing depends on the washing conditions. The aqueous extract of medical masks washed at home through one to five cycles has a different pH. A sample of the medical mask washed through five cycles has an almost 1.8 pH units higher value than after a single wash. The aqueous extract of medical masks washed through one to five cycles under laboratory conditions is alkaline, with all the samples having almost the same value (pH 8.9).
The pH of the aqueous extract of the cut mask samples before washing at the same temperature was 0.5 pH units lower than that of the whole mask sample. The obtained results show that the washed cut mask samples have a more alkaline aqueous extract compared to the whole mask samples, which could be due to residual alkalis within the nonwoven structure, which has a higher migration potential away from the structure when the samples are cut.
3.2.1. Surfactants Residuals Characterization
In accordance with the hypotheses highlighted in [
19], decontamination methods should not only demonstrate effective pathogen reduction but also preserve the properties of medical masks without harmful chemical effects for the user. In accordance with that, the whole and cut mask samples were analyzed for the presence and content of surfactants before and after the first and fifth wash cycle, depending on the composition of the applied detergents and DDAC.
Medical masks not subjected to washing (N) were analyzed by determining all surfactants, ionic (anionic and cationic), and nonionic.
The home-washed samples were analyzed by determining the anionic and nonionic surfactants, while the laboratory-washed samples with the addition of DDAC in the rinse were analyzed by determining the anionic, cationic, and nonionic surfactants.
The results of potentiometric determination of residues of anionic surfactants in the aqueous extract of whole medical masks before and after washing are shown in
Table 10.
The results of the amount of surfactants in the whole mask samples,
Table 10, show the presence of ionic and nonionic surfactants only in some samples. The whole mask samples contained all surfactants before washing, with an extremely high amount of anionic surfactants and a much lower amount of nonionic and cationic surfactants compared to the anionic ones. The reason for this can indeed be attributed to contamination during production/packaging and/or an analysis error. The obtained amounts of cationic and nonionic surfactant per mass of the sample do not differ significantly, and in terms of residuals their values are lower than the permissible values according to the quality system, RAL-GZ 992.
In the 1× home-washed sample (H 1×), the anionic surfactant was isolated. Cumulative washing cycles had no effect on the increase in the residual amount of surfactants but eliminated them completely (H 5×).
There was a change after the laboratory washing of the whole mask samples compared to the unwashed whole mask samples, which can be concluded from the presence of the anionic surfactant in the 1× washed sample (L 1×) and a nonionic surfactant in the 5× washed sample (L 5×). Washing in the laboratory with a standard detergent and rinsing with the addition of DDAC (LDS) affected the state of the surface so that anionic and cationic surfactants were present after the first and fifth cycles, and their amount increased with the number of cycles, indicating the cumulative aggregation of surfactants.
Considering the potential and actual interactions of ionic surfactants (anionic and cationic) in the same bath, their combination on textiles is not common. However, in the performed procedure, where DDAC was added as a cationic surfactant in the fourth rinse cycle (after washing with standard detergent and the third rinse cycle in water), it partially reduced the amount of anionic surfactant, without eliminating it completely.
A conceptually identical analysis was performed on the cut mask samples (U), with the combined results of the surfactant analysis on the medical mask samples presented in
Table 11.
Surfactant residuals were found in the unwashed and washed samples, and their values were within the limits set by the control system RAL-GZ 992. It is better to perform the analysis of the parameters on whole samples than on cut samples. The surfactant content results of the cut medical mask samples listed in
Table 11 are significantly different from those listed in
Table 10. Cationic surfactants were found only in the unwashed medical mask sample, and their amount was twice smaller than for the whole sample. According to this analysis, the cationic surfactant identified in the unwashed sample of the whole and cut medical masks indicates the possible addition of this surfactant during production as an additive to provide antimicrobial activity. The anionic surfactant was found on all the cut samples of the medical masks, and its amount was below the permissible levels (400 µg/g) according to RAL-GZ 992.
The nonionic surfactant was found in three samples (L U 1×, LDS U 1×, LDS U 5×), and its amount was not higher than the permissible amount (200 µg/g) according to RAL-GZ.
In summary, the FTIR analysis results confirmed that the back and front nonwoven layers of medical masks were made of polypropylene, and that the washing procedures had an unfavorable influence on the spectral values of the medical masks (fastness evaluation 3–4), through which the aesthetic properties of the masks were slightly damaged.
The new packaged masks are microbiologically safe; significant contamination occurs during home washing, whereas it is considerably lower during laboratory washing. The addition of a disinfectant in the fourth rinse has a favorable effect on microbiological efficiency, and no microorganisms are present. The increase in the pH of the surface of the medical masks washed through five cycles under laboratory conditions is due to the alkalinity of the standard detergent solution. The aqueous extract of the medical masks washed at home and under laboratory conditions through five cycles is alkaline, with almost the same value (pH 8.9) found for all samples.
It is better to perform the analysis on the whole samples than on the cut ones.
The nonwoven structure of the medical mask and the wrinkles that form during washing make it difficult to perform the analysis.
By applying the hierarchical cluster analysis (HCA) [
42] to the results of air permeability, contact angle, and whiteness of the samples, a group distribution was obtained,
Figure 10.
The group distribution highlights the unwashed sample, and there is a greater distance between the samples washed 1× in the household washing machine. The highlighting of these samples confirms the earlier claim about the significantly different influence of the mechanics of the household washing machine compared to the laboratory washing device,
Figure 10. The influence of the number of washing cycles on the observed parameters was additionally confirmed.
The similarities and differences between the groups show and confirm the claims about the impact of washing on the contact angle, which primarily depends on the number of wash cycles performed.
The static contact angle, air permeability, and FTIR results demonstrated the reusability and washability of medical masks at 50 °C in home and laboratory washing procedures. It was also confirmed that washed masks contain minimal amounts of residue, so contact with skin is not hazardous. The spectral properties of the washed masks changed slightly due to bleeding of the color during the washing process. The added benefit of the proposed approach was the use of the disinfectant didecyldimethylammonium chloride in the washing process.